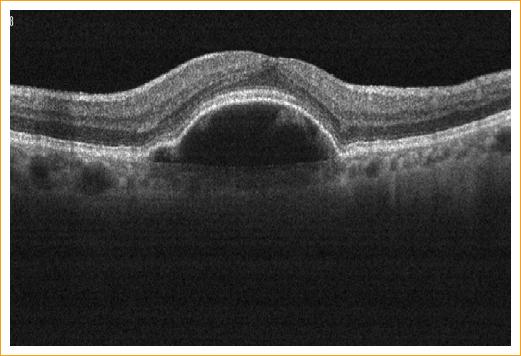

Introduction
Posterior capsule opacification is the most frequent cause of decreased visual acuity after cataract surgery and can occur in up to 25% of patients at 5 years1.
The mechanisms involved in its appearance are the type of intraocular lens (IOL) used, a small capsulorhexis, the type of IOL edge and posterior capsule polishing2,3.
Nd-YAG laser, for its acronym in English neodymium-doped yttrium aluminum garnet, is currently an excellent therapy in the management of posterior capsule opacification4,5.
It is a laser emission device with a wavelength of 1,064 nanometers (nm) that can disintegrate ocular tissues and generate an optical breakdown with a short pulse of high power. This optical breakdown results in an ionization phenomena and plasma formation in the ocular tissue. This plasma formation causes acoustic and shock waves that promote tissue disintegration6,7.
Performing a posterior capsulotomy is indicated when visual acuity is reduced, affecting the performance of everyday activities or when it is impossible to explore the posterior pole structures like the retina or the optic nerve8,9.
As is to be expected, it is not free of complications. Among the reported are damage to the IOL, intraocular pressure (IOP) elevation, cystoid macular edema, retinal detachment, endophthalmitis, iritis, vitritis, macular holes and corneal edema.
IOP increase is the most frequent complication and it is usually transient. Elevations greater than 10 mmHg have been observed in 15-67% of the eyes. IOP increase is immediate, with a peak at 3-4 h that begins to decrease at 24 h, although it can persist up to a week. Acute elevations can affect visual acuity. An association between major elevations and pre-existing glaucoma, capsulotomy size, sulcus or posterior chamber fixation of the IOL, myopia, retinal disease and cumulative energy has been reported. Some of the mechanisms described are the decrease in aqueous filtration by capsular debris, accumulation of inflammatory cells, liquefied vitreous and trabecular damage by shock waves. All patients with risk factors should be monitored closely and prescribed antihypertensive and anti-inflammatory prophylactic treatment.
Within the posterior segment complications, cystoid macular edema has been reported in 0.55-2.5% and may occur 3 to 11 months after the posterior capsulotomy. Retinal detachment has been reported in 0.08-3.6%. It can occur immediately after the posterior capsulotomy or years later10.
Damage to the IOL occurs in 15-33%. It is more frequent if the IOL is adhered to the posterior capsule or if the opacity is thick. The dotting or marks in the optics can cause glare and depends on the IOL material. The damage threshold is lower for silicone lenses, intermediate for PMMA and high for acrylic11.
One of the most feared and troublesome complications is endophthalmitis. Propionibacterium acnes has been reported as a causative agent. The mechanism is the creation of a pathway for the bacteria of the posterior capsule to the vitreous12.
Results
We present the case of a 70-year-old patient with a 8-year history of systemic arterial hypertension treated with captopril, with cataract surgery of the right eye (OD) 17 years ago and IOL removal 3 years later (the cause is unknown). He also has a history of cataract surgery in the left eye (OS) 3 years ago.
He came 48 hours after a posterior capsulotomy with Nd-YAG laser, referring pain and conjunctival hyperemia in OS, and hemicranial headache and vagal symptoms.
On exploration we found a visual acuity (VA) on OD of counting fingers 30 cm * 20/400, and on OS of 20/60 * NI (no improvement). In the OD, clear cornea with extracapsular extraction scars is observed, normal anterior chamber with gonioscopy 4-4-4-4, patent iridectomy at M11, round and central pupil, aphakia, vitreous syneresis, applied retina, healthy vasculature, macular drusen, excavation of 6/10, pale optic nerve with temporal atrophy and an IOP of 12 mmHg.
The OS showed hyperemic bulbar conjunctiva ++, reactive pupil, edematous cornea, descemet striae, apparent endothelial micro blebs, reactive pupil, gonioscopy ISNT 4-4-4-4 with pigment ++, vitreous in the anterior chamber with corneal endothelial touch, trace cells, normal iris, IOL subluxation, applied retina, macular drusen and apparent elevation of the foveolar retina, pale optic nerve with excavation 7/10, visible lamina cribrosa, peripapillary atrophy and IOP of 34 mmHg.
Immediate management of IOP is initiated with oral acetazolamide as a single-dose 250 mg tablet (Acetadiazol®, Laboratorios Grin), as well as one drop of brimonidine, timolol, dorzolamide as a single-dose (2 mg, 5 mg, 20 mg/mL Krytantek Ofteno®, Sophia) plus one drop of 1% prednisolone as a single-dose (Sophipren Ofteno®). For corneal edema, 5% sodium chloride (5% Hiperton®) and deflazacort 1 mg/kg/day (Calcort® 30 mg, Sanofi) 2 tablets every 24 h are started. Appropriate IOP control is achieved at 8 mmHg.
In the medical records there is a visit registered one month before, stating that the patient was sent to the glaucoma department due to suspicious optic disc excavations. A visual field was not completed due to an untreated anxiety disorder, so an OS capsulotomy is performed and a subsequent glaucoma optical coherence tomography (OCT) is requested to continue studying the patient. This visit describes the OS exploration with a clear cornea, anterior chamber without the presence of vitreous and macular drusen in the posterior pole. This led us to conclude that the findings in the current visit were highly suggestive of complications related to the posterior capsulotomy. The capsulotomy description reported 42 shots with a power of 2.4 mJ and a capsulotomy size of 5 mm, obtaining a free visual axis.
OCT is performed finding a retinal pigment epithelial detachment (RPED) associated with subretinal fluid with a central macular thickness of 257 µ. Retinal nerve fiber layer (RNFL) average of 97.13 in OD and 122.49 in OS. Central pachymetry of 624 µ (Fig. 1).
In the follow-up OCT, resolution of subretinal fluid with RPED persistence was observed (Figs. 2 y 3). Resolution of the corneal endothelial touch was observed (Figs. 4-6). The comparison of the RNFL during the phase of ocular hypertension and the follow-up at 3 days, at one week and at 3 months, showed an important thickening pattern in all the quadrants, except for the superior temporal and inferior temporal quadrants, which showed almost no increase (Fig. 7).
The corneal endothelium was analyzed, with an OD count of 1,578 cells/mm2, hexagonality of 57%; OS 1,263 cells/mm2, hexagonality of 83%.
We decided to perform a vitrectomy 4 months later (delayed for economic reasons), as well as adaptation of a scleral lens in the OD with aphakia and conservative management of IOL subluxation. Eight months later, the patient had a pachymetry of 508 µ (Fig. 8), with resolution of the subretinal fluid but with RPED persistence. The corrected visual acuity was 20/40-2 and IOP in OS was 12 mmHg without antihypertensive or anti-inflammatory treatment.
Discussion
The potential mechanisms of increased IOP are inflammation secondary to the application of Nd-YAG laser, relative pupillary block due to IOL subluxation and vitreous prolapse into the anterior chamber, as well as angle closure from vitreous prolapse. A steroid-induced glaucoma cannot be ruled out, since the IOP increase and pain occurred 24 to 48 h after initiating prednisolone as a routine medication for capsulotomy, and a week after its discontinuation there was an IOP decrease, even without hypotensive medications (Fig. 9).
Posterior pole complications such as RPED are less frequent, with only one case reported in a patient with age-related macular degeneration treated with antiangiogenic therapy13.
As a result of the analysis and follow-up of the RNFL (Fig. 8) the MARIAH Study was created based on the name of patient number 1 (María), and due to its acronym in English: «Measurement and Analysis of RNFL and IOP pattern during and after Acute angle-closure glaucoma and Hypertensive eyes», which aimed to 1) analyze the quadrants most sensitive to IOP increase, 2) search for a gradient that associates the mmHg increase with microns affectation in the RNFL and 3) compare the severity between the peak IOP and the number of days with elevated IOP.










nueva página del texto (beta)